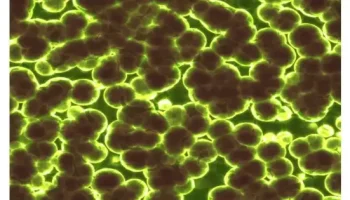

Copper catalysts have been shown to be effective in converting carbon dioxide (CO2) into useful liquid fuels such as methanol and ethanol. Recently, a team
Researchers have made a huge, engineered study that shows what we can anticipate from the Nancy-Beauty-Roman Space Telescope's future perceptions. However, it addresses simply a little lump of the genuine
An examination group from Kiel College depicts an obscure guard system in microbes that specifically avoids unfamiliar and possibly unsafe hereditary data. Since the COVID pandemic, the especially fast developmental
A new exploration from the Netherlands Foundation for Neuroscience reveals insight into how the cerebrum shuffles ethically clashing results during learning. "Individuals who picked their own benefit to the detriment
Graphite is a critical material used in the production of lithium-ion batteries, which are used to power electric vehicles and store renewable energy. Currently, China dominates the graphite market, accounting